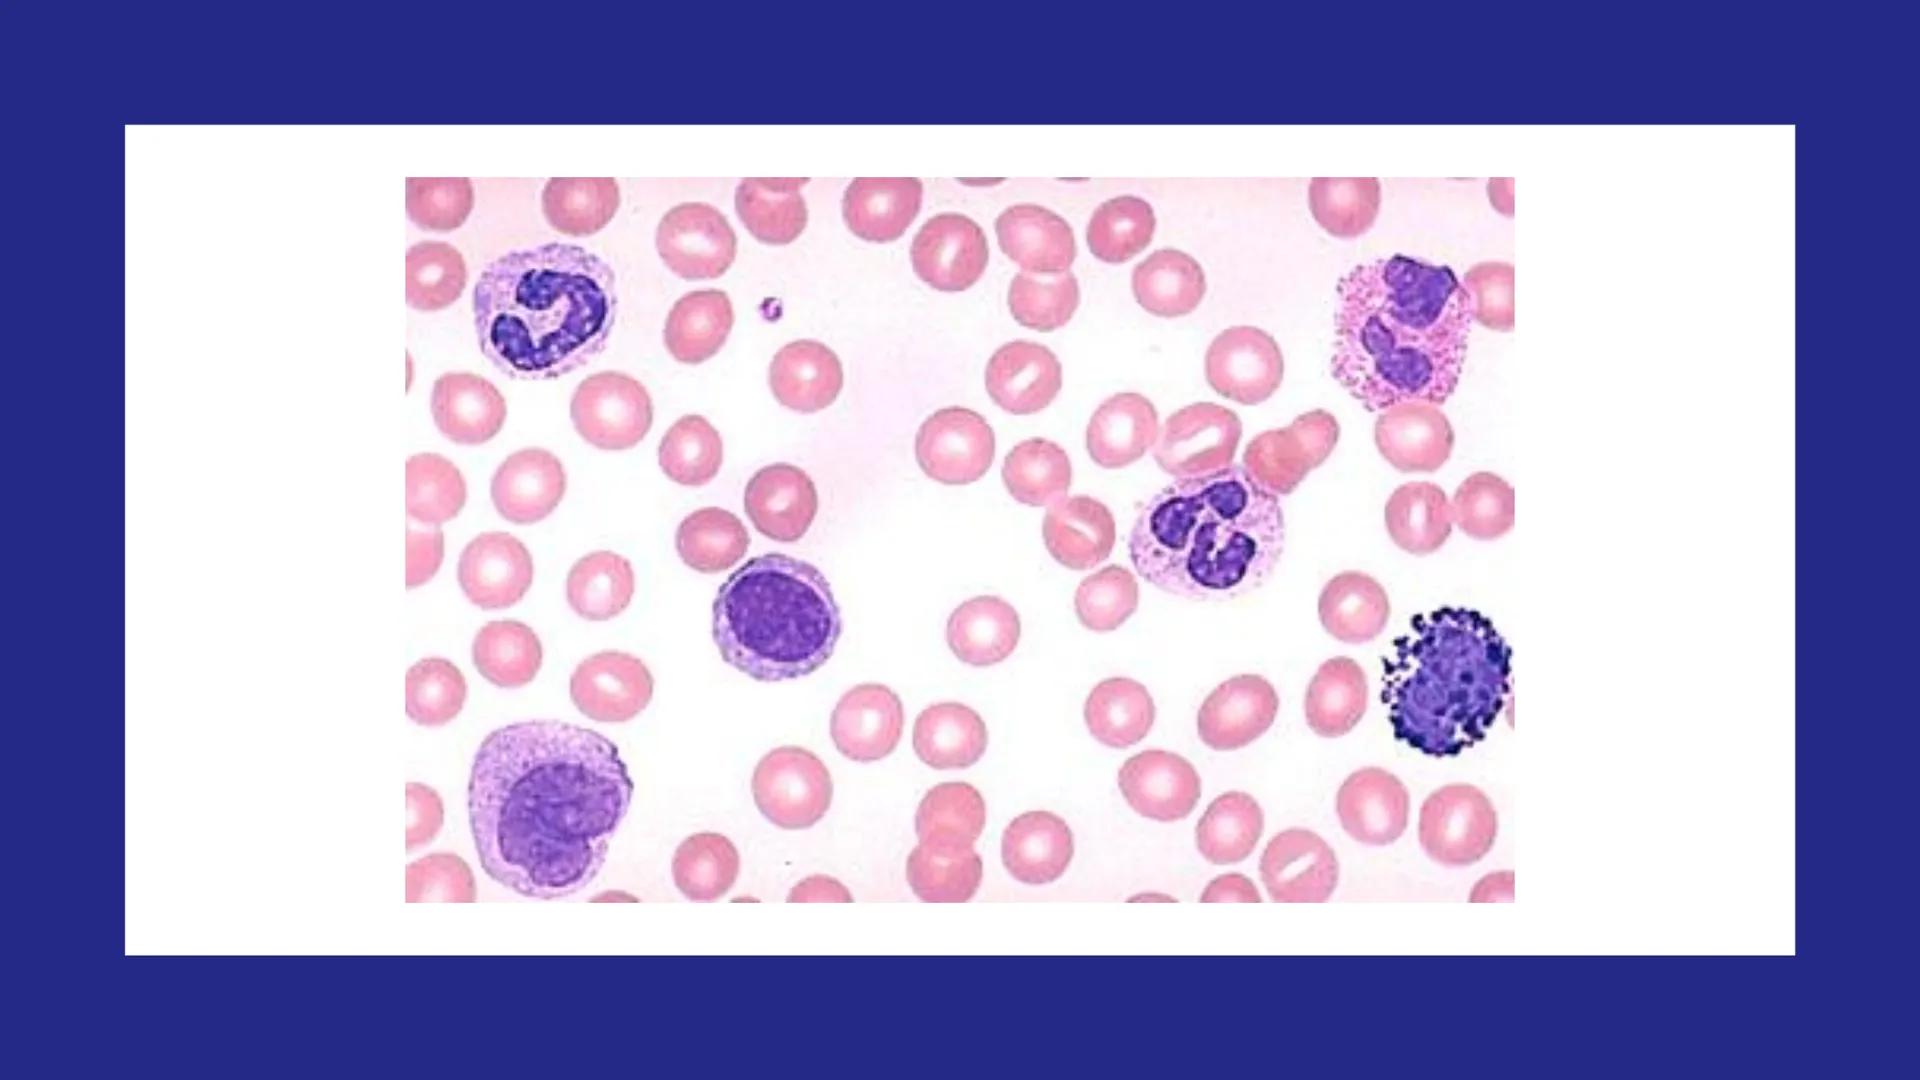
# SANGRE Y MÉDULA ÓSEA
Es tejido conjuntivo líquido que circula a través del aparato cardiovascular FUNCIONES
Transporte de sustancias nut

La sangre es un tejido conjuntivo líquido vital que recorre... Mostrar más
Inscríbete para ver los apuntes¡Es gratis!
Acceso a todos los documentos
Mejora tus notas
Únete a millones de estudiantes
Knowunity AI
Asignaturas
Triangle Congruence and Similarity Theorems
Triangle Properties and Classification
Linear Equations and Graphs
Geometric Angle Relationships
Trigonometric Functions and Identities
Equation Solving Techniques
Circle Geometry Fundamentals
Division Operations and Methods
Basic Differentiation Rules
Exponent and Logarithm Properties
Mostrar todos los temas
Human Organ Systems
Reproductive Cell Cycles
Biological Sciences Subdisciplines
Cellular Energy Metabolism
Autotrophic Energy Processes
Inheritance Patterns and Principles
Biomolecular Structure and Organization
Cell Cycle and Division Mechanics
Cellular Organization and Development
Biological Structural Organization
Mostrar todos los temas
Chemical Sciences and Applications
Atomic Structure and Composition
Molecular Electron Structure Representation
Atomic Electron Behavior
Matter Properties and Water
Mole Concept and Calculations
Gas Laws and Behavior
Periodic Table Organization
Chemical Thermodynamics Fundamentals
Chemical Bond Types and Properties
Mostrar todos los temas
European Renaissance and Enlightenment
European Cultural Movements 800-1920
American Revolution Era 1763-1797
American Civil War 1861-1865
Global Imperial Systems
Mongol and Chinese Dynasties
U.S. Presidents and World Leaders
Historical Sources and Documentation
World Wars Era and Impact
World Religious Systems
Mostrar todos los temas
Classic and Contemporary Novels
Literary Character Analysis
Rhetorical Theory and Practice
Classic Literary Narratives
Reading Analysis and Interpretation
Narrative Structure and Techniques
English Language Components
Influential English-Language Authors
Basic Sentence Structure
Narrative Voice and Perspective
Mostrar todos los temas
109
•
Actualizado Apr 6, 2026
•
Arlette Castillo
@arlettecastillo
La sangre es un tejido conjuntivo líquido vital que recorre... Mostrar más

























La sangre es un tejido conjuntivo líquido especializado que circula constantemente a través del aparato cardiovascular. A diferencia de otros tejidos, este se encuentra en estado fluido, lo que le permite transportarse por todo el cuerpo.
Este tejido es producido principalmente en la médula ósea, un órgano esencial para la formación de células sanguíneas.
💡 ¡Dato interesante! La sangre es el único tejido del cuerpo humano que se encuentra en estado líquido, lo que le permite llegar a cada célula del organismo.

La sangre realiza múltiples funciones vitales que mantienen vivo nuestro organismo. Transporta nutrientes y oxígeno desde los sistemas digestivo y respiratorio hacia todas las células del cuerpo, asegurando su supervivencia.
Además, es responsable de recoger los desechos celulares y el dióxido de carbono, llevándolos a los órganos encargados de su eliminación. Distribuye hormonas y otras sustancias reguladoras por todo el cuerpo, permitiendo la comunicación entre órganos.
La sangre juega un papel crucial en el mantenimiento de la homeostasis, regulando la temperatura corporal, el pH y el equilibrio de electrolitos. También transporta células y agentes humorales del sistema inmunitario, defendiéndonos de patógenos.
💡 Recuerda: La homeostasis es la capacidad del cuerpo para mantener un ambiente interno estable a pesar de los cambios externos.

La sangre está compuesta por diferentes tipos de células que cumplen funciones específicas: eritrocitos (glóbulos rojos), leucocitos (glóbulos blancos) y trombocitos (plaquetas).
El volumen de estas células en la sangre se mide mediante el hematocrito, que representa entre el 45-55% del volumen sanguíneo total. Existen diferencias normales entre hombres (39-50%) y mujeres (35-45%) debido a factores hormonales.
El plasma constituye el componente líquido donde flotan las células sanguíneas, siendo 90% agua. Las plaquetas y leucocitos ocupan apenas el 1% del volumen total, mientras que los glóbulos rojos conforman la mayor parte del volumen celular.
💡 Importante: Las diferencias en el hematocrito entre hombres y mujeres son normales y se deben principalmente a la influencia hormonal, especialmente de la testosterona que estimula la producción de glóbulos rojos.

La albúmina se sintetiza en el hígado y es fundamental para crear un gradiente de concentración en la sangre. Esta proteína mantiene la presión coloidosmótica, evitando que el líquido se escape de los vasos sanguíneos. También funciona como proteína transportadora de diversas sustancias.
Este grupo incluye las inmunoglobulinas esenciales para la defensa inmunológica, y las globulinas no inmunes (alfa y beta). Participan en el mantenimiento de la presión osmótica y actúan como transportadoras. Entre otras, encontramos fibronectina, lipoproteínas y factores de coagulación.
Es la proteína plasmática más grande, también sintetizada en el hígado. Su importancia radica en que se transforma en fibrina durante el proceso de coagulación, formando una red que atrapa células y detiene hemorragias.
💡 Dato clave: Cuando el hígado sufre daños graves, la producción de estas proteínas disminuye, lo que puede provocar edemas (por falta de albúmina) y problemas de coagulación (por déficit de fibrinógeno).

El eritrocito o glóbulo rojo es una célula sanguínea especializada que carece de núcleo (anucleada), lo que le permite transportar más hemoglobina. Su función se limita exclusivamente al torrente sanguíneo, sin migrar a los tejidos.
Presenta una característica forma de disco bicóncavo con un diámetro de 7.8 μm, 2.6 μm en el borde y solo 0.8 μm en su centro. Esta forma aumenta su superficie de contacto para el intercambio de gases y le permite ser deformable para atravesar capilares más estrechos que su propio diámetro.
Cada eritrocito tiene una vida media de aproximadamente 120 días, tras los cuales es eliminado principalmente por el bazo cuando pierde su elasticidad o capacidad de transporte de oxígeno.
💡 ¡Sorprendente! La forma bicóncava del eritrocito le permite aumentar su superficie hasta un 30% en comparación con una esfera del mismo volumen, maximizando su capacidad de intercambio gaseoso.

La membrana del eritrocito contiene importantes proteínas como las glucoforinas y la proteína banda 3. La glucoforina C es especialmente importante para la adhesión de la membrana celular a la red proteica del citoesqueleto, mientras que la banda 3 fija la hemoglobina a la membrana.
La hemoglobina es la proteína responsable del transporte de oxígeno y dióxido de carbono. Está formada por cadenas polipeptídicas (α, β, γ, δ) y un grupo hemo que contiene hierro, el cual se une directamente al oxígeno.
En adultos, existen diferentes tipos de hemoglobina: la Hb A representa el 96% (dos cadenas α y dos β), la Hb A2 constituye el 1.5-3% (dos cadenas α y dos δ), y la Hb F apenas el 1% (dos cadenas α y dos γ). Esta última predomina en el feto y aparece aumentada en condiciones como drepanocitosis y talasemia.
💡 Importante para exámenes: La hemoglobina F tiene mayor afinidad por el oxígeno que la hemoglobina A, lo que permite al feto "robar" oxígeno de la sangre materna durante el desarrollo.

Las proteínas periféricas se localizan en la superficie interna de la membrana del eritrocito y son fundamentales para su funcionamiento correcto. Su distribución específica es responsable de la característica forma bicóncava del glóbulo rojo y le confiere las propiedades elásticas necesarias para atravesar capilares estrechos.
Entre estas proteínas destaca la espectrina, cuya deficiencia provoca la esferocitosis hereditaria, donde los glóbulos rojos adoptan forma esférica, volviéndose más frágiles y propensos a la hemólisis.
Otra proteína importante es la banda 4.1, relacionada con la eliptocitosis hereditaria, condición en la que los eritrocitos presentan forma elíptica o alargada, afectando su función y vida media.
💡 Conexión clínica: Las alteraciones en estas proteínas periféricas explican por qué algunas anemias hereditarias no se deben a deficiencias de hemoglobina, sino a problemas estructurales de la membrana del eritrocito.

Los leucocitos se clasifican en granulocitos y agranulocitos según la presencia de gránulos específicos en su citoplasma. El neutrófilo es el leucocito más abundante en sangre, midiendo entre 10-12 μm.
Una característica distintiva del neutrófilo es su núcleo segmentado con múltiples lobulaciones , por lo que también se les conoce como polimorfonucleares (PMN). En mujeres, puede observarse el corpúsculo de Barr (cromatina sexual).
Los neutrófilos contienen varios tipos de gránulos:
💡 Dato clínico: Un aumento en el número de neutrófilos (neutrofilia) suele indicar infecciones bacterianas agudas, mientras que su disminución (neutropenia) puede ser signo de infecciones virales o enfermedades autoinmunes.

Los neutrófilos son fagocitos activos que juegan un papel crucial en la respuesta inflamatoria. Cuando detectan una infección, abandonan el torrente sanguíneo y migran al tejido conjuntivo donde se encuentra el agente patógeno.
Durante la inflamación, liberan pirógeno que contribuye a la fiebre, un mecanismo de defensa que dificulta la proliferación bacteriana. Su migración desde los vasos sanguíneos hasta los sitios de infección es un proceso complejo que involucra moléculas de adhesión como selectinas, integrinas, ICAM-1 y VCAM-1.
Los neutrófilos también contienen histamina y heparina, que participan en la regulación de la respuesta inflamatoria. Una vez en el tejido, reconocen y fagocitan microorganismos, los digieren mediante enzimas líticas y liberan sustancias antimicrobianas.
💡 Visualízalo así: Los neutrófilos funcionan como el "ejército de primera respuesta" del cuerpo, llegando rápidamente al sitio de infección y sacrificándose en el proceso de defender al organismo, formando lo que conocemos como pus.

El eosinófilo es un leucocito más grande que el neutrófilo y fácilmente identificable por su núcleo característicamente bilobulado y sus abundantes gránulos específicos que se tiñen intensamente con colorantes ácidos como la eosina.
Sus gránulos específicos son grandes y alargados, contienen proteínas como la proteína básica mayor (MBP), proteína catiónica eosinofílica (ECP) y peroxidasa eosinofílica (EPO), todas con efecto citotóxico contra parásitos. También contienen neurotoxina derivada del eosinófilo (EDN) que puede causar disfunción del sistema nervioso.
Además poseen gránulos azurófilos que contienen lisosomas y enzimas hidrolíticas que participan en la destrucción de parásitos. Producen enzimas como arisulfatasa e histaminasa, que contrarrestan los efectos de mediadores inflamatorios como los leucotrienos y la histamina.
💡 Conexión clínica: El aumento de eosinófilos (eosinofilia) es característico de alergias, asma y parasitosis. Por eso, cuando aparecen elevados en un análisis de sangre, el médico suele sospechar de estas condiciones.














Nuestro compañero de IA está específicamente adaptado a las necesidades de los estudiantes. Basándonos en los millones de contenidos que tenemos en la plataforma, podemos dar a los estudiantes respuestas realmente significativas y relevantes. Pero no se trata solo de respuestas, el compañero también guía a los estudiantes a través de sus retos de aprendizaje diarios, con planes de aprendizaje personalizados, cuestionarios o contenidos en el chat y una personalización del 100% basada en las habilidades y el desarrollo de los estudiantes.
Puedes descargar la app en Google Play Store y Apple App Store.
¡Sí lo es! Tienes acceso totalmente gratuito a todo el contenido de la app, puedes chatear con otros alumnos y recibir ayuda inmeditamente. Puedes ganar dinero utilizando la aplicación, que te permitirá acceder a determinadas funciones.
App Store
Google Play
La app es muy fácil de usar y está muy bien diseñada. Hasta ahora he encontrado todo lo que estaba buscando y he podido aprender mucho de las presentaciones. Definitivamente utilizaré la aplicación para un examen de clase. Y, por supuesto, también me sirve mucho de inspiración.
Pablo
usuario de iOS
Esta app es realmente genial. Hay tantos apuntes de clase y ayuda [...]. Tengo problemas con matemáticas, por ejemplo, y la aplicación tiene muchas opciones de ayuda. Gracias a Knowunity, he mejorado en mates. Se la recomiendo a todo el mundo.
Elena
usuaria de Android
Vaya, estoy realmente sorprendida. Acabo de probar la app porque la he visto anunciada muchas veces y me he quedado absolutamente alucinada. Esta app es LA AYUDA que quieres para el insti y, sobre todo, ofrece muchísimas cosas, como ejercicios y hojas informativas, que a mí personalmente me han sido MUY útiles.
Ana
usuaria de iOS
Solía tener dificultades para completar mis tareas a tiempo hasta que descubrí Knowunity, que no solo facilita subir mi propio contenido sino que también proporciona excelentes resúmenes que hacen mi trabajo más rápido y eficiente.
Thomas R
usuario de iOS
Siempre era un desafío encontrar toda la información importante para mis tareas – desde que comencé a usar Knowunity, puedo simplemente subir mi contenido y beneficiarme de los resúmenes de otros, lo que me ayuda mucho con la organización.
Lisa M
usuario de Android
A menudo sentía que no tenía suficiente visión general al estudiar, pero desde que comencé a usar Knowunity, eso ya no es un problema – subo mi contenido y siempre encuentro resúmenes útiles en la plataforma, lo que hace mi aprendizaje mucho más fácil.
David K
usuario de iOS
¡La app es buenísima! Sólo tengo que introducir el tema en la barra de búsqueda y recibo la respuesta muy rápido. No tengo que ver 10 vídeos de YouTube para entender algo, así que me ahorro tiempo. ¡Muy recomendable!
Sara
usuaria de Android
En el instituto era muy malo en matemáticas, pero gracias a la app, ahora saco mejores notas. Os agradezco mucho que hayáis creado la aplicación.
Roberto
usuario de Android
Solía ser muy difícil reunir toda la información para mis presentaciones. Pero desde que comencé a usar Knowunity, solo subo mis notas y encuentro increíbles resúmenes de otros – ¡hace mi estudio mucho más eficiente!
Julia S
usuario de Android
Siempre estaba estresado con todo el material de estudio, pero desde que comencé a usar Knowunity, subo mis cosas y reviso los geniales resúmenes de otros – realmente me ayuda a manejar todo mejor y es mucho menos estresante.
Marco B
usuario de iOS
LOS QUIZZES Y FLASHCARDS SON SÚPER ÚTILES Y AMO Knowunity AI. TAMBIÉN ES LITERALMENTE COMO CHATGPT PERO MÁS INTELIGENTE!! ME AYUDÓ CON MIS PROBLEMAS DE RÍMEL TAMBIÉN!! Y CON MIS MATERIAS REALES OBVIO! 😍😁😲🤑💗✨🎀😮
Sarah L
usuario de Android
Antes pasaba horas buscando en Google materiales escolares, pero ahora solo subo mis cosas a Knowunity y reviso los útiles resúmenes de otros – me siento mucho más seguro cuando me preparo para los exámenes.
Paul T
usuario de iOS
La app es muy fácil de usar y está muy bien diseñada. Hasta ahora he encontrado todo lo que estaba buscando y he podido aprender mucho de las presentaciones. Definitivamente utilizaré la aplicación para un examen de clase. Y, por supuesto, también me sirve mucho de inspiración.
Pablo
usuario de iOS
Esta app es realmente genial. Hay tantos apuntes de clase y ayuda [...]. Tengo problemas con matemáticas, por ejemplo, y la aplicación tiene muchas opciones de ayuda. Gracias a Knowunity, he mejorado en mates. Se la recomiendo a todo el mundo.
Elena
usuaria de Android
Vaya, estoy realmente sorprendida. Acabo de probar la app porque la he visto anunciada muchas veces y me he quedado absolutamente alucinada. Esta app es LA AYUDA que quieres para el insti y, sobre todo, ofrece muchísimas cosas, como ejercicios y hojas informativas, que a mí personalmente me han sido MUY útiles.
Ana
usuaria de iOS
Solía tener dificultades para completar mis tareas a tiempo hasta que descubrí Knowunity, que no solo facilita subir mi propio contenido sino que también proporciona excelentes resúmenes que hacen mi trabajo más rápido y eficiente.
Thomas R
usuario de iOS
Siempre era un desafío encontrar toda la información importante para mis tareas – desde que comencé a usar Knowunity, puedo simplemente subir mi contenido y beneficiarme de los resúmenes de otros, lo que me ayuda mucho con la organización.
Lisa M
usuario de Android
A menudo sentía que no tenía suficiente visión general al estudiar, pero desde que comencé a usar Knowunity, eso ya no es un problema – subo mi contenido y siempre encuentro resúmenes útiles en la plataforma, lo que hace mi aprendizaje mucho más fácil.
David K
usuario de iOS
¡La app es buenísima! Sólo tengo que introducir el tema en la barra de búsqueda y recibo la respuesta muy rápido. No tengo que ver 10 vídeos de YouTube para entender algo, así que me ahorro tiempo. ¡Muy recomendable!
Sara
usuaria de Android
En el instituto era muy malo en matemáticas, pero gracias a la app, ahora saco mejores notas. Os agradezco mucho que hayáis creado la aplicación.
Roberto
usuario de Android
Solía ser muy difícil reunir toda la información para mis presentaciones. Pero desde que comencé a usar Knowunity, solo subo mis notas y encuentro increíbles resúmenes de otros – ¡hace mi estudio mucho más eficiente!
Julia S
usuario de Android
Siempre estaba estresado con todo el material de estudio, pero desde que comencé a usar Knowunity, subo mis cosas y reviso los geniales resúmenes de otros – realmente me ayuda a manejar todo mejor y es mucho menos estresante.
Marco B
usuario de iOS
LOS QUIZZES Y FLASHCARDS SON SÚPER ÚTILES Y AMO Knowunity AI. TAMBIÉN ES LITERALMENTE COMO CHATGPT PERO MÁS INTELIGENTE!! ME AYUDÓ CON MIS PROBLEMAS DE RÍMEL TAMBIÉN!! Y CON MIS MATERIAS REALES OBVIO! 😍😁😲🤑💗✨🎀😮
Sarah L
usuario de Android
Antes pasaba horas buscando en Google materiales escolares, pero ahora solo subo mis cosas a Knowunity y reviso los útiles resúmenes de otros – me siento mucho más seguro cuando me preparo para los exámenes.
Paul T
usuario de iOS
Arlette Castillo
@arlettecastillo
La sangre es un tejido conjuntivo líquido vital que recorre todo nuestro sistema cardiovascular. Este fluido extraordinario cumple múltiples funciones esenciales para mantener nuestro organismo funcionando correctamente. Conocer sus componentes y formación nos ayuda a entender cómo se mantiene la... Mostrar más

Acceso a todos los documentos
Mejora tus notas
Únete a millones de estudiantes
La sangre es un tejido conjuntivo líquido especializado que circula constantemente a través del aparato cardiovascular. A diferencia de otros tejidos, este se encuentra en estado fluido, lo que le permite transportarse por todo el cuerpo.
Este tejido es producido principalmente en la médula ósea, un órgano esencial para la formación de células sanguíneas.
💡 ¡Dato interesante! La sangre es el único tejido del cuerpo humano que se encuentra en estado líquido, lo que le permite llegar a cada célula del organismo.

Acceso a todos los documentos
Mejora tus notas
Únete a millones de estudiantes
La sangre realiza múltiples funciones vitales que mantienen vivo nuestro organismo. Transporta nutrientes y oxígeno desde los sistemas digestivo y respiratorio hacia todas las células del cuerpo, asegurando su supervivencia.
Además, es responsable de recoger los desechos celulares y el dióxido de carbono, llevándolos a los órganos encargados de su eliminación. Distribuye hormonas y otras sustancias reguladoras por todo el cuerpo, permitiendo la comunicación entre órganos.
La sangre juega un papel crucial en el mantenimiento de la homeostasis, regulando la temperatura corporal, el pH y el equilibrio de electrolitos. También transporta células y agentes humorales del sistema inmunitario, defendiéndonos de patógenos.
💡 Recuerda: La homeostasis es la capacidad del cuerpo para mantener un ambiente interno estable a pesar de los cambios externos.

Acceso a todos los documentos
Mejora tus notas
Únete a millones de estudiantes
La sangre está compuesta por diferentes tipos de células que cumplen funciones específicas: eritrocitos (glóbulos rojos), leucocitos (glóbulos blancos) y trombocitos (plaquetas).
El volumen de estas células en la sangre se mide mediante el hematocrito, que representa entre el 45-55% del volumen sanguíneo total. Existen diferencias normales entre hombres (39-50%) y mujeres (35-45%) debido a factores hormonales.
El plasma constituye el componente líquido donde flotan las células sanguíneas, siendo 90% agua. Las plaquetas y leucocitos ocupan apenas el 1% del volumen total, mientras que los glóbulos rojos conforman la mayor parte del volumen celular.
💡 Importante: Las diferencias en el hematocrito entre hombres y mujeres son normales y se deben principalmente a la influencia hormonal, especialmente de la testosterona que estimula la producción de glóbulos rojos.

Acceso a todos los documentos
Mejora tus notas
Únete a millones de estudiantes
La albúmina se sintetiza en el hígado y es fundamental para crear un gradiente de concentración en la sangre. Esta proteína mantiene la presión coloidosmótica, evitando que el líquido se escape de los vasos sanguíneos. También funciona como proteína transportadora de diversas sustancias.
Este grupo incluye las inmunoglobulinas esenciales para la defensa inmunológica, y las globulinas no inmunes (alfa y beta). Participan en el mantenimiento de la presión osmótica y actúan como transportadoras. Entre otras, encontramos fibronectina, lipoproteínas y factores de coagulación.
Es la proteína plasmática más grande, también sintetizada en el hígado. Su importancia radica en que se transforma en fibrina durante el proceso de coagulación, formando una red que atrapa células y detiene hemorragias.
💡 Dato clave: Cuando el hígado sufre daños graves, la producción de estas proteínas disminuye, lo que puede provocar edemas (por falta de albúmina) y problemas de coagulación (por déficit de fibrinógeno).

Acceso a todos los documentos
Mejora tus notas
Únete a millones de estudiantes
El eritrocito o glóbulo rojo es una célula sanguínea especializada que carece de núcleo (anucleada), lo que le permite transportar más hemoglobina. Su función se limita exclusivamente al torrente sanguíneo, sin migrar a los tejidos.
Presenta una característica forma de disco bicóncavo con un diámetro de 7.8 μm, 2.6 μm en el borde y solo 0.8 μm en su centro. Esta forma aumenta su superficie de contacto para el intercambio de gases y le permite ser deformable para atravesar capilares más estrechos que su propio diámetro.
Cada eritrocito tiene una vida media de aproximadamente 120 días, tras los cuales es eliminado principalmente por el bazo cuando pierde su elasticidad o capacidad de transporte de oxígeno.
💡 ¡Sorprendente! La forma bicóncava del eritrocito le permite aumentar su superficie hasta un 30% en comparación con una esfera del mismo volumen, maximizando su capacidad de intercambio gaseoso.

Acceso a todos los documentos
Mejora tus notas
Únete a millones de estudiantes
La membrana del eritrocito contiene importantes proteínas como las glucoforinas y la proteína banda 3. La glucoforina C es especialmente importante para la adhesión de la membrana celular a la red proteica del citoesqueleto, mientras que la banda 3 fija la hemoglobina a la membrana.
La hemoglobina es la proteína responsable del transporte de oxígeno y dióxido de carbono. Está formada por cadenas polipeptídicas (α, β, γ, δ) y un grupo hemo que contiene hierro, el cual se une directamente al oxígeno.
En adultos, existen diferentes tipos de hemoglobina: la Hb A representa el 96% (dos cadenas α y dos β), la Hb A2 constituye el 1.5-3% (dos cadenas α y dos δ), y la Hb F apenas el 1% (dos cadenas α y dos γ). Esta última predomina en el feto y aparece aumentada en condiciones como drepanocitosis y talasemia.
💡 Importante para exámenes: La hemoglobina F tiene mayor afinidad por el oxígeno que la hemoglobina A, lo que permite al feto "robar" oxígeno de la sangre materna durante el desarrollo.

Acceso a todos los documentos
Mejora tus notas
Únete a millones de estudiantes
Las proteínas periféricas se localizan en la superficie interna de la membrana del eritrocito y son fundamentales para su funcionamiento correcto. Su distribución específica es responsable de la característica forma bicóncava del glóbulo rojo y le confiere las propiedades elásticas necesarias para atravesar capilares estrechos.
Entre estas proteínas destaca la espectrina, cuya deficiencia provoca la esferocitosis hereditaria, donde los glóbulos rojos adoptan forma esférica, volviéndose más frágiles y propensos a la hemólisis.
Otra proteína importante es la banda 4.1, relacionada con la eliptocitosis hereditaria, condición en la que los eritrocitos presentan forma elíptica o alargada, afectando su función y vida media.
💡 Conexión clínica: Las alteraciones en estas proteínas periféricas explican por qué algunas anemias hereditarias no se deben a deficiencias de hemoglobina, sino a problemas estructurales de la membrana del eritrocito.

Acceso a todos los documentos
Mejora tus notas
Únete a millones de estudiantes
Los leucocitos se clasifican en granulocitos y agranulocitos según la presencia de gránulos específicos en su citoplasma. El neutrófilo es el leucocito más abundante en sangre, midiendo entre 10-12 μm.
Una característica distintiva del neutrófilo es su núcleo segmentado con múltiples lobulaciones , por lo que también se les conoce como polimorfonucleares (PMN). En mujeres, puede observarse el corpúsculo de Barr (cromatina sexual).
Los neutrófilos contienen varios tipos de gránulos:
💡 Dato clínico: Un aumento en el número de neutrófilos (neutrofilia) suele indicar infecciones bacterianas agudas, mientras que su disminución (neutropenia) puede ser signo de infecciones virales o enfermedades autoinmunes.

Acceso a todos los documentos
Mejora tus notas
Únete a millones de estudiantes
Los neutrófilos son fagocitos activos que juegan un papel crucial en la respuesta inflamatoria. Cuando detectan una infección, abandonan el torrente sanguíneo y migran al tejido conjuntivo donde se encuentra el agente patógeno.
Durante la inflamación, liberan pirógeno que contribuye a la fiebre, un mecanismo de defensa que dificulta la proliferación bacteriana. Su migración desde los vasos sanguíneos hasta los sitios de infección es un proceso complejo que involucra moléculas de adhesión como selectinas, integrinas, ICAM-1 y VCAM-1.
Los neutrófilos también contienen histamina y heparina, que participan en la regulación de la respuesta inflamatoria. Una vez en el tejido, reconocen y fagocitan microorganismos, los digieren mediante enzimas líticas y liberan sustancias antimicrobianas.
💡 Visualízalo así: Los neutrófilos funcionan como el "ejército de primera respuesta" del cuerpo, llegando rápidamente al sitio de infección y sacrificándose en el proceso de defender al organismo, formando lo que conocemos como pus.

Acceso a todos los documentos
Mejora tus notas
Únete a millones de estudiantes
El eosinófilo es un leucocito más grande que el neutrófilo y fácilmente identificable por su núcleo característicamente bilobulado y sus abundantes gránulos específicos que se tiñen intensamente con colorantes ácidos como la eosina.
Sus gránulos específicos son grandes y alargados, contienen proteínas como la proteína básica mayor (MBP), proteína catiónica eosinofílica (ECP) y peroxidasa eosinofílica (EPO), todas con efecto citotóxico contra parásitos. También contienen neurotoxina derivada del eosinófilo (EDN) que puede causar disfunción del sistema nervioso.
Además poseen gránulos azurófilos que contienen lisosomas y enzimas hidrolíticas que participan en la destrucción de parásitos. Producen enzimas como arisulfatasa e histaminasa, que contrarrestan los efectos de mediadores inflamatorios como los leucotrienos y la histamina.
💡 Conexión clínica: El aumento de eosinófilos (eosinofilia) es característico de alergias, asma y parasitosis. Por eso, cuando aparecen elevados en un análisis de sangre, el médico suele sospechar de estas condiciones.

Acceso a todos los documentos
Mejora tus notas
Únete a millones de estudiantes

Acceso a todos los documentos
Mejora tus notas
Únete a millones de estudiantes

Acceso a todos los documentos
Mejora tus notas
Únete a millones de estudiantes
Acceso a todos los documentos
Mejora tus notas
Únete a millones de estudiantes

Acceso a todos los documentos
Mejora tus notas
Únete a millones de estudiantes

Acceso a todos los documentos
Mejora tus notas
Únete a millones de estudiantes

Acceso a todos los documentos
Mejora tus notas
Únete a millones de estudiantes

Acceso a todos los documentos
Mejora tus notas
Únete a millones de estudiantes

Acceso a todos los documentos
Mejora tus notas
Únete a millones de estudiantes

Acceso a todos los documentos
Mejora tus notas
Únete a millones de estudiantes

Acceso a todos los documentos
Mejora tus notas
Únete a millones de estudiantes

Acceso a todos los documentos
Mejora tus notas
Únete a millones de estudiantes

Acceso a todos los documentos
Mejora tus notas
Únete a millones de estudiantes

Acceso a todos los documentos
Mejora tus notas
Únete a millones de estudiantes
Nuestro compañero de IA está específicamente adaptado a las necesidades de los estudiantes. Basándonos en los millones de contenidos que tenemos en la plataforma, podemos dar a los estudiantes respuestas realmente significativas y relevantes. Pero no se trata solo de respuestas, el compañero también guía a los estudiantes a través de sus retos de aprendizaje diarios, con planes de aprendizaje personalizados, cuestionarios o contenidos en el chat y una personalización del 100% basada en las habilidades y el desarrollo de los estudiantes.
Puedes descargar la app en Google Play Store y Apple App Store.
¡Sí lo es! Tienes acceso totalmente gratuito a todo el contenido de la app, puedes chatear con otros alumnos y recibir ayuda inmeditamente. Puedes ganar dinero utilizando la aplicación, que te permitirá acceder a determinadas funciones.
2
Herramientas Inteligentes NUEVO
Convierte estos apuntes en: ✓ 50+ Preguntas de Práctica ✓ Tarjetas de Estudio Interactivas ✓ Examen Completo de Práctica ✓ Esquemas de Ensayo
App Store
Google Play
La app es muy fácil de usar y está muy bien diseñada. Hasta ahora he encontrado todo lo que estaba buscando y he podido aprender mucho de las presentaciones. Definitivamente utilizaré la aplicación para un examen de clase. Y, por supuesto, también me sirve mucho de inspiración.
Pablo
usuario de iOS
Esta app es realmente genial. Hay tantos apuntes de clase y ayuda [...]. Tengo problemas con matemáticas, por ejemplo, y la aplicación tiene muchas opciones de ayuda. Gracias a Knowunity, he mejorado en mates. Se la recomiendo a todo el mundo.
Elena
usuaria de Android
Vaya, estoy realmente sorprendida. Acabo de probar la app porque la he visto anunciada muchas veces y me he quedado absolutamente alucinada. Esta app es LA AYUDA que quieres para el insti y, sobre todo, ofrece muchísimas cosas, como ejercicios y hojas informativas, que a mí personalmente me han sido MUY útiles.
Ana
usuaria de iOS
Solía tener dificultades para completar mis tareas a tiempo hasta que descubrí Knowunity, que no solo facilita subir mi propio contenido sino que también proporciona excelentes resúmenes que hacen mi trabajo más rápido y eficiente.
Thomas R
usuario de iOS
Siempre era un desafío encontrar toda la información importante para mis tareas – desde que comencé a usar Knowunity, puedo simplemente subir mi contenido y beneficiarme de los resúmenes de otros, lo que me ayuda mucho con la organización.
Lisa M
usuario de Android
A menudo sentía que no tenía suficiente visión general al estudiar, pero desde que comencé a usar Knowunity, eso ya no es un problema – subo mi contenido y siempre encuentro resúmenes útiles en la plataforma, lo que hace mi aprendizaje mucho más fácil.
David K
usuario de iOS
¡La app es buenísima! Sólo tengo que introducir el tema en la barra de búsqueda y recibo la respuesta muy rápido. No tengo que ver 10 vídeos de YouTube para entender algo, así que me ahorro tiempo. ¡Muy recomendable!
Sara
usuaria de Android
En el instituto era muy malo en matemáticas, pero gracias a la app, ahora saco mejores notas. Os agradezco mucho que hayáis creado la aplicación.
Roberto
usuario de Android
Solía ser muy difícil reunir toda la información para mis presentaciones. Pero desde que comencé a usar Knowunity, solo subo mis notas y encuentro increíbles resúmenes de otros – ¡hace mi estudio mucho más eficiente!
Julia S
usuario de Android
Siempre estaba estresado con todo el material de estudio, pero desde que comencé a usar Knowunity, subo mis cosas y reviso los geniales resúmenes de otros – realmente me ayuda a manejar todo mejor y es mucho menos estresante.
Marco B
usuario de iOS
LOS QUIZZES Y FLASHCARDS SON SÚPER ÚTILES Y AMO Knowunity AI. TAMBIÉN ES LITERALMENTE COMO CHATGPT PERO MÁS INTELIGENTE!! ME AYUDÓ CON MIS PROBLEMAS DE RÍMEL TAMBIÉN!! Y CON MIS MATERIAS REALES OBVIO! 😍😁😲🤑💗✨🎀😮
Sarah L
usuario de Android
Antes pasaba horas buscando en Google materiales escolares, pero ahora solo subo mis cosas a Knowunity y reviso los útiles resúmenes de otros – me siento mucho más seguro cuando me preparo para los exámenes.
Paul T
usuario de iOS
La app es muy fácil de usar y está muy bien diseñada. Hasta ahora he encontrado todo lo que estaba buscando y he podido aprender mucho de las presentaciones. Definitivamente utilizaré la aplicación para un examen de clase. Y, por supuesto, también me sirve mucho de inspiración.
Pablo
usuario de iOS
Esta app es realmente genial. Hay tantos apuntes de clase y ayuda [...]. Tengo problemas con matemáticas, por ejemplo, y la aplicación tiene muchas opciones de ayuda. Gracias a Knowunity, he mejorado en mates. Se la recomiendo a todo el mundo.
Elena
usuaria de Android
Vaya, estoy realmente sorprendida. Acabo de probar la app porque la he visto anunciada muchas veces y me he quedado absolutamente alucinada. Esta app es LA AYUDA que quieres para el insti y, sobre todo, ofrece muchísimas cosas, como ejercicios y hojas informativas, que a mí personalmente me han sido MUY útiles.
Ana
usuaria de iOS
Solía tener dificultades para completar mis tareas a tiempo hasta que descubrí Knowunity, que no solo facilita subir mi propio contenido sino que también proporciona excelentes resúmenes que hacen mi trabajo más rápido y eficiente.
Thomas R
usuario de iOS
Siempre era un desafío encontrar toda la información importante para mis tareas – desde que comencé a usar Knowunity, puedo simplemente subir mi contenido y beneficiarme de los resúmenes de otros, lo que me ayuda mucho con la organización.
Lisa M
usuario de Android
A menudo sentía que no tenía suficiente visión general al estudiar, pero desde que comencé a usar Knowunity, eso ya no es un problema – subo mi contenido y siempre encuentro resúmenes útiles en la plataforma, lo que hace mi aprendizaje mucho más fácil.
David K
usuario de iOS
¡La app es buenísima! Sólo tengo que introducir el tema en la barra de búsqueda y recibo la respuesta muy rápido. No tengo que ver 10 vídeos de YouTube para entender algo, así que me ahorro tiempo. ¡Muy recomendable!
Sara
usuaria de Android
En el instituto era muy malo en matemáticas, pero gracias a la app, ahora saco mejores notas. Os agradezco mucho que hayáis creado la aplicación.
Roberto
usuario de Android
Solía ser muy difícil reunir toda la información para mis presentaciones. Pero desde que comencé a usar Knowunity, solo subo mis notas y encuentro increíbles resúmenes de otros – ¡hace mi estudio mucho más eficiente!
Julia S
usuario de Android
Siempre estaba estresado con todo el material de estudio, pero desde que comencé a usar Knowunity, subo mis cosas y reviso los geniales resúmenes de otros – realmente me ayuda a manejar todo mejor y es mucho menos estresante.
Marco B
usuario de iOS
LOS QUIZZES Y FLASHCARDS SON SÚPER ÚTILES Y AMO Knowunity AI. TAMBIÉN ES LITERALMENTE COMO CHATGPT PERO MÁS INTELIGENTE!! ME AYUDÓ CON MIS PROBLEMAS DE RÍMEL TAMBIÉN!! Y CON MIS MATERIAS REALES OBVIO! 😍😁😲🤑💗✨🎀😮
Sarah L
usuario de Android
Antes pasaba horas buscando en Google materiales escolares, pero ahora solo subo mis cosas a Knowunity y reviso los útiles resúmenes de otros – me siento mucho más seguro cuando me preparo para los exámenes.
Paul T
usuario de iOS